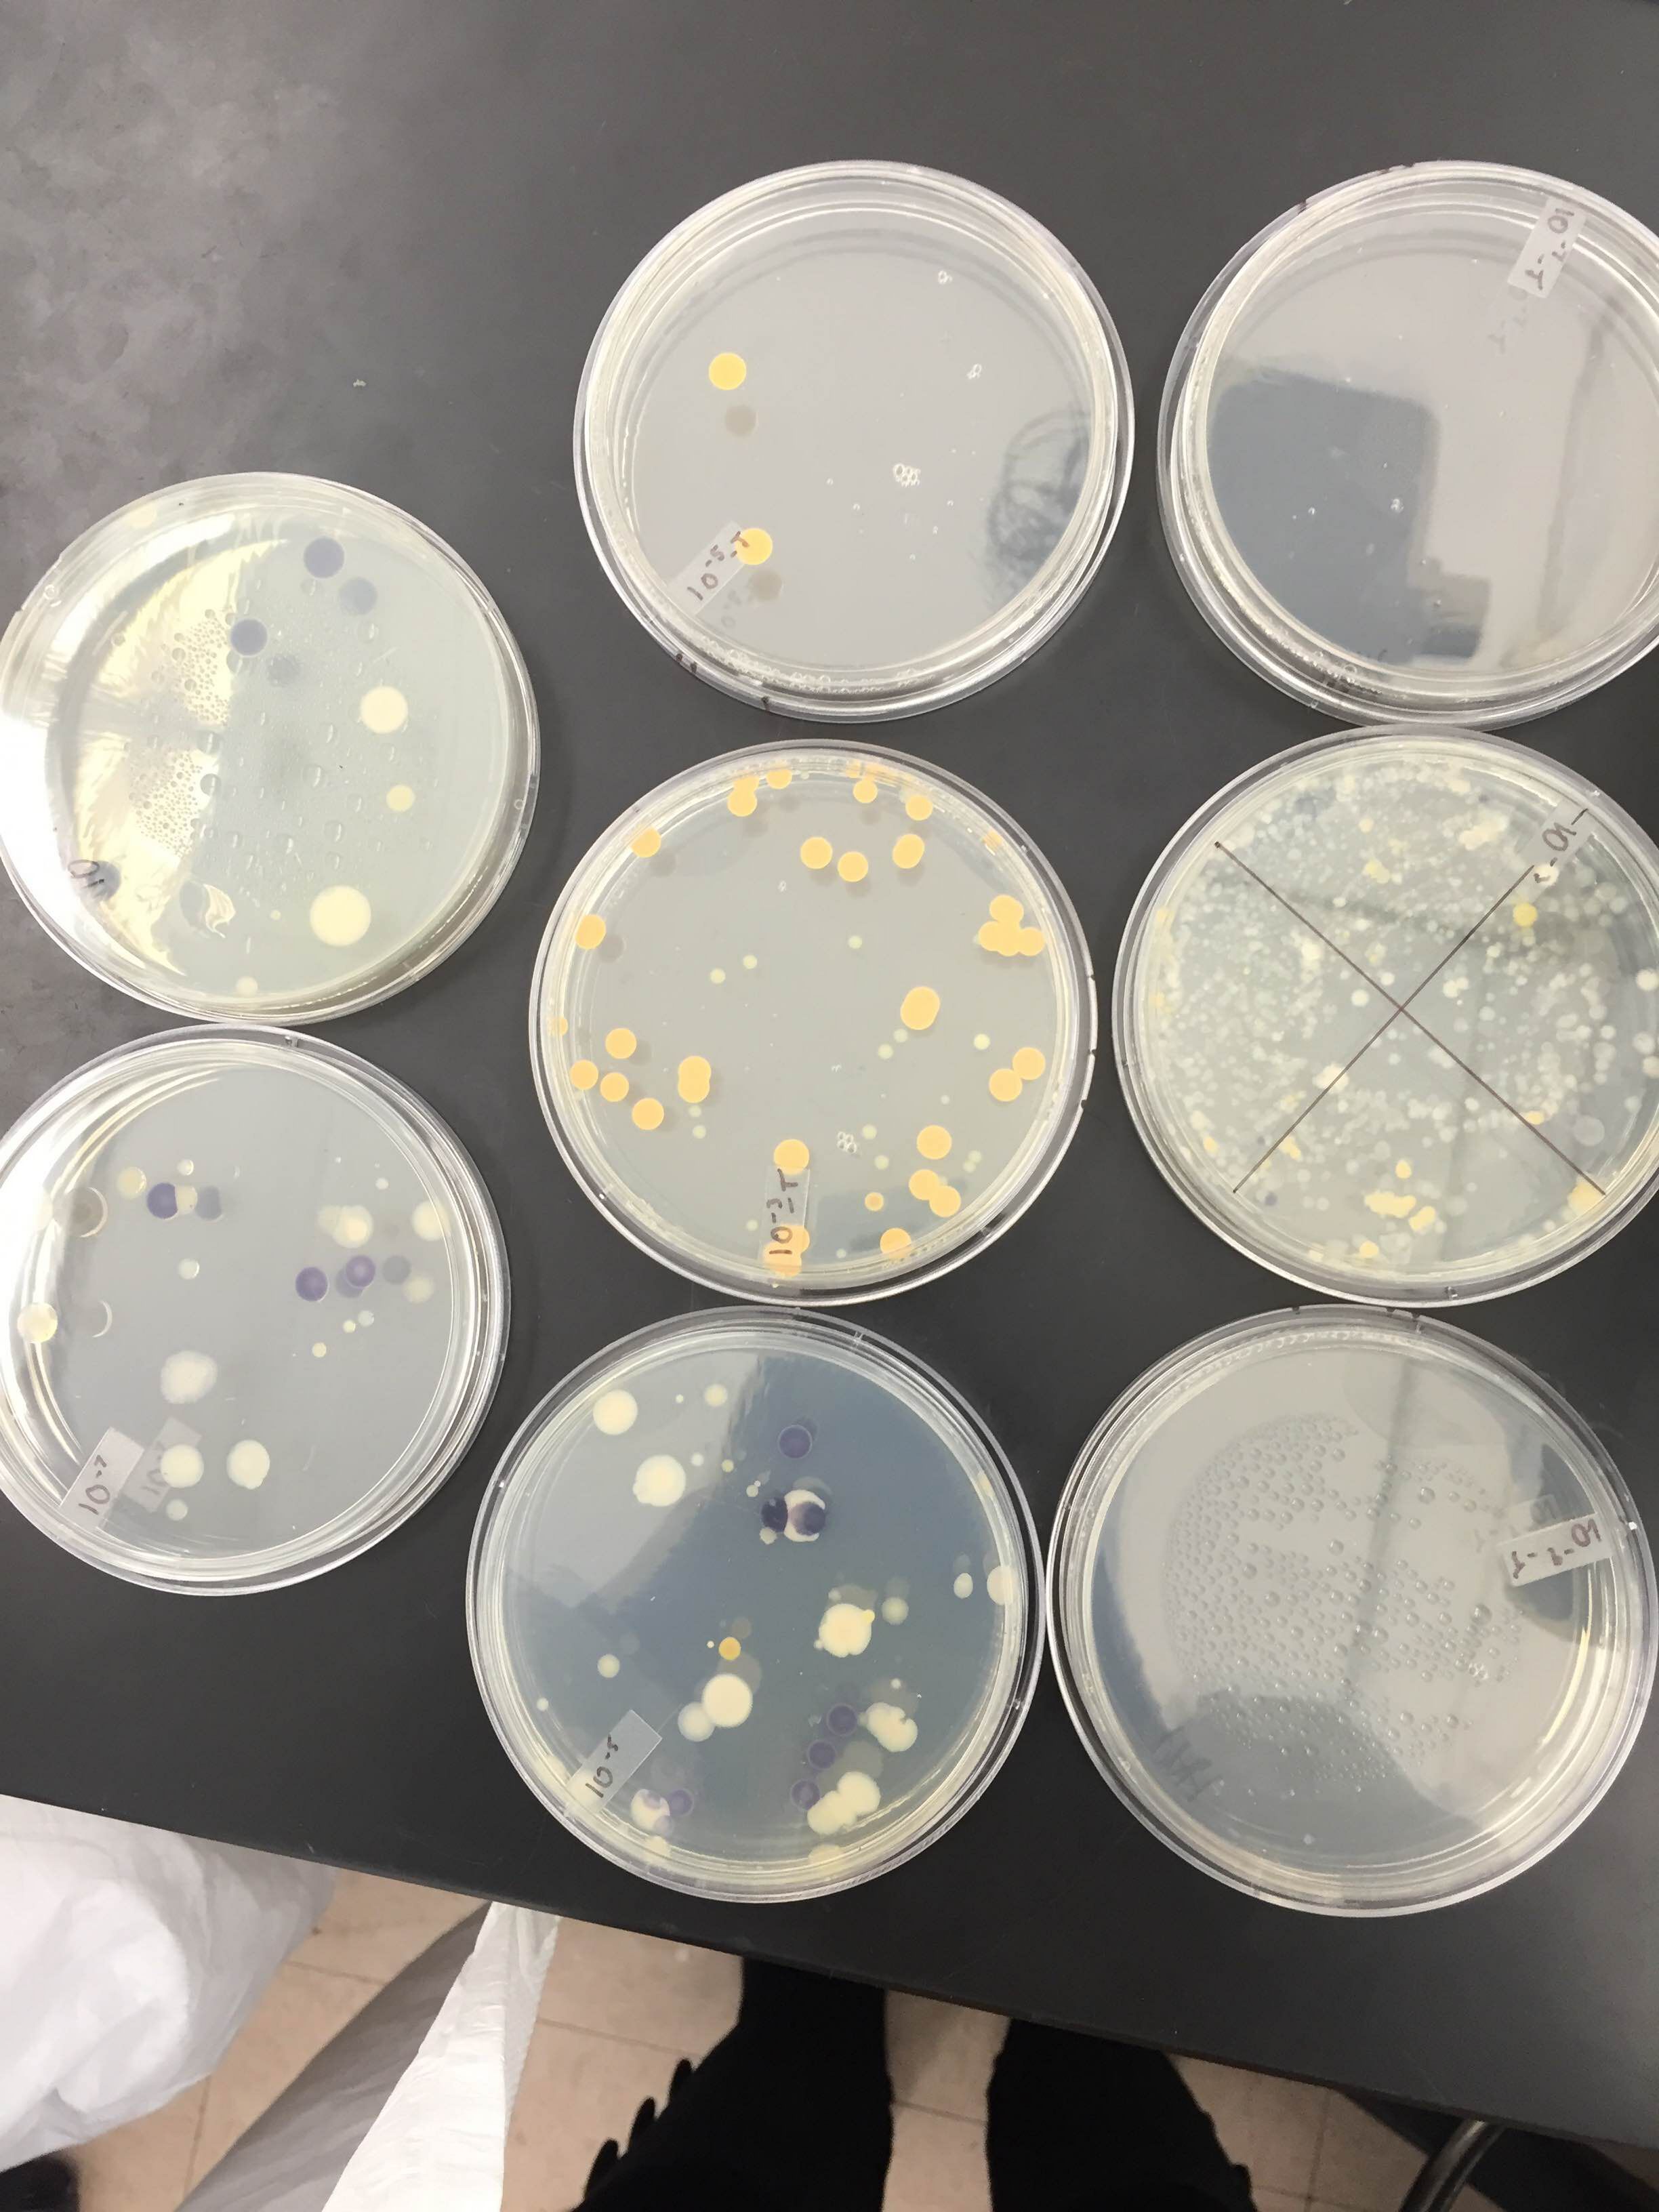
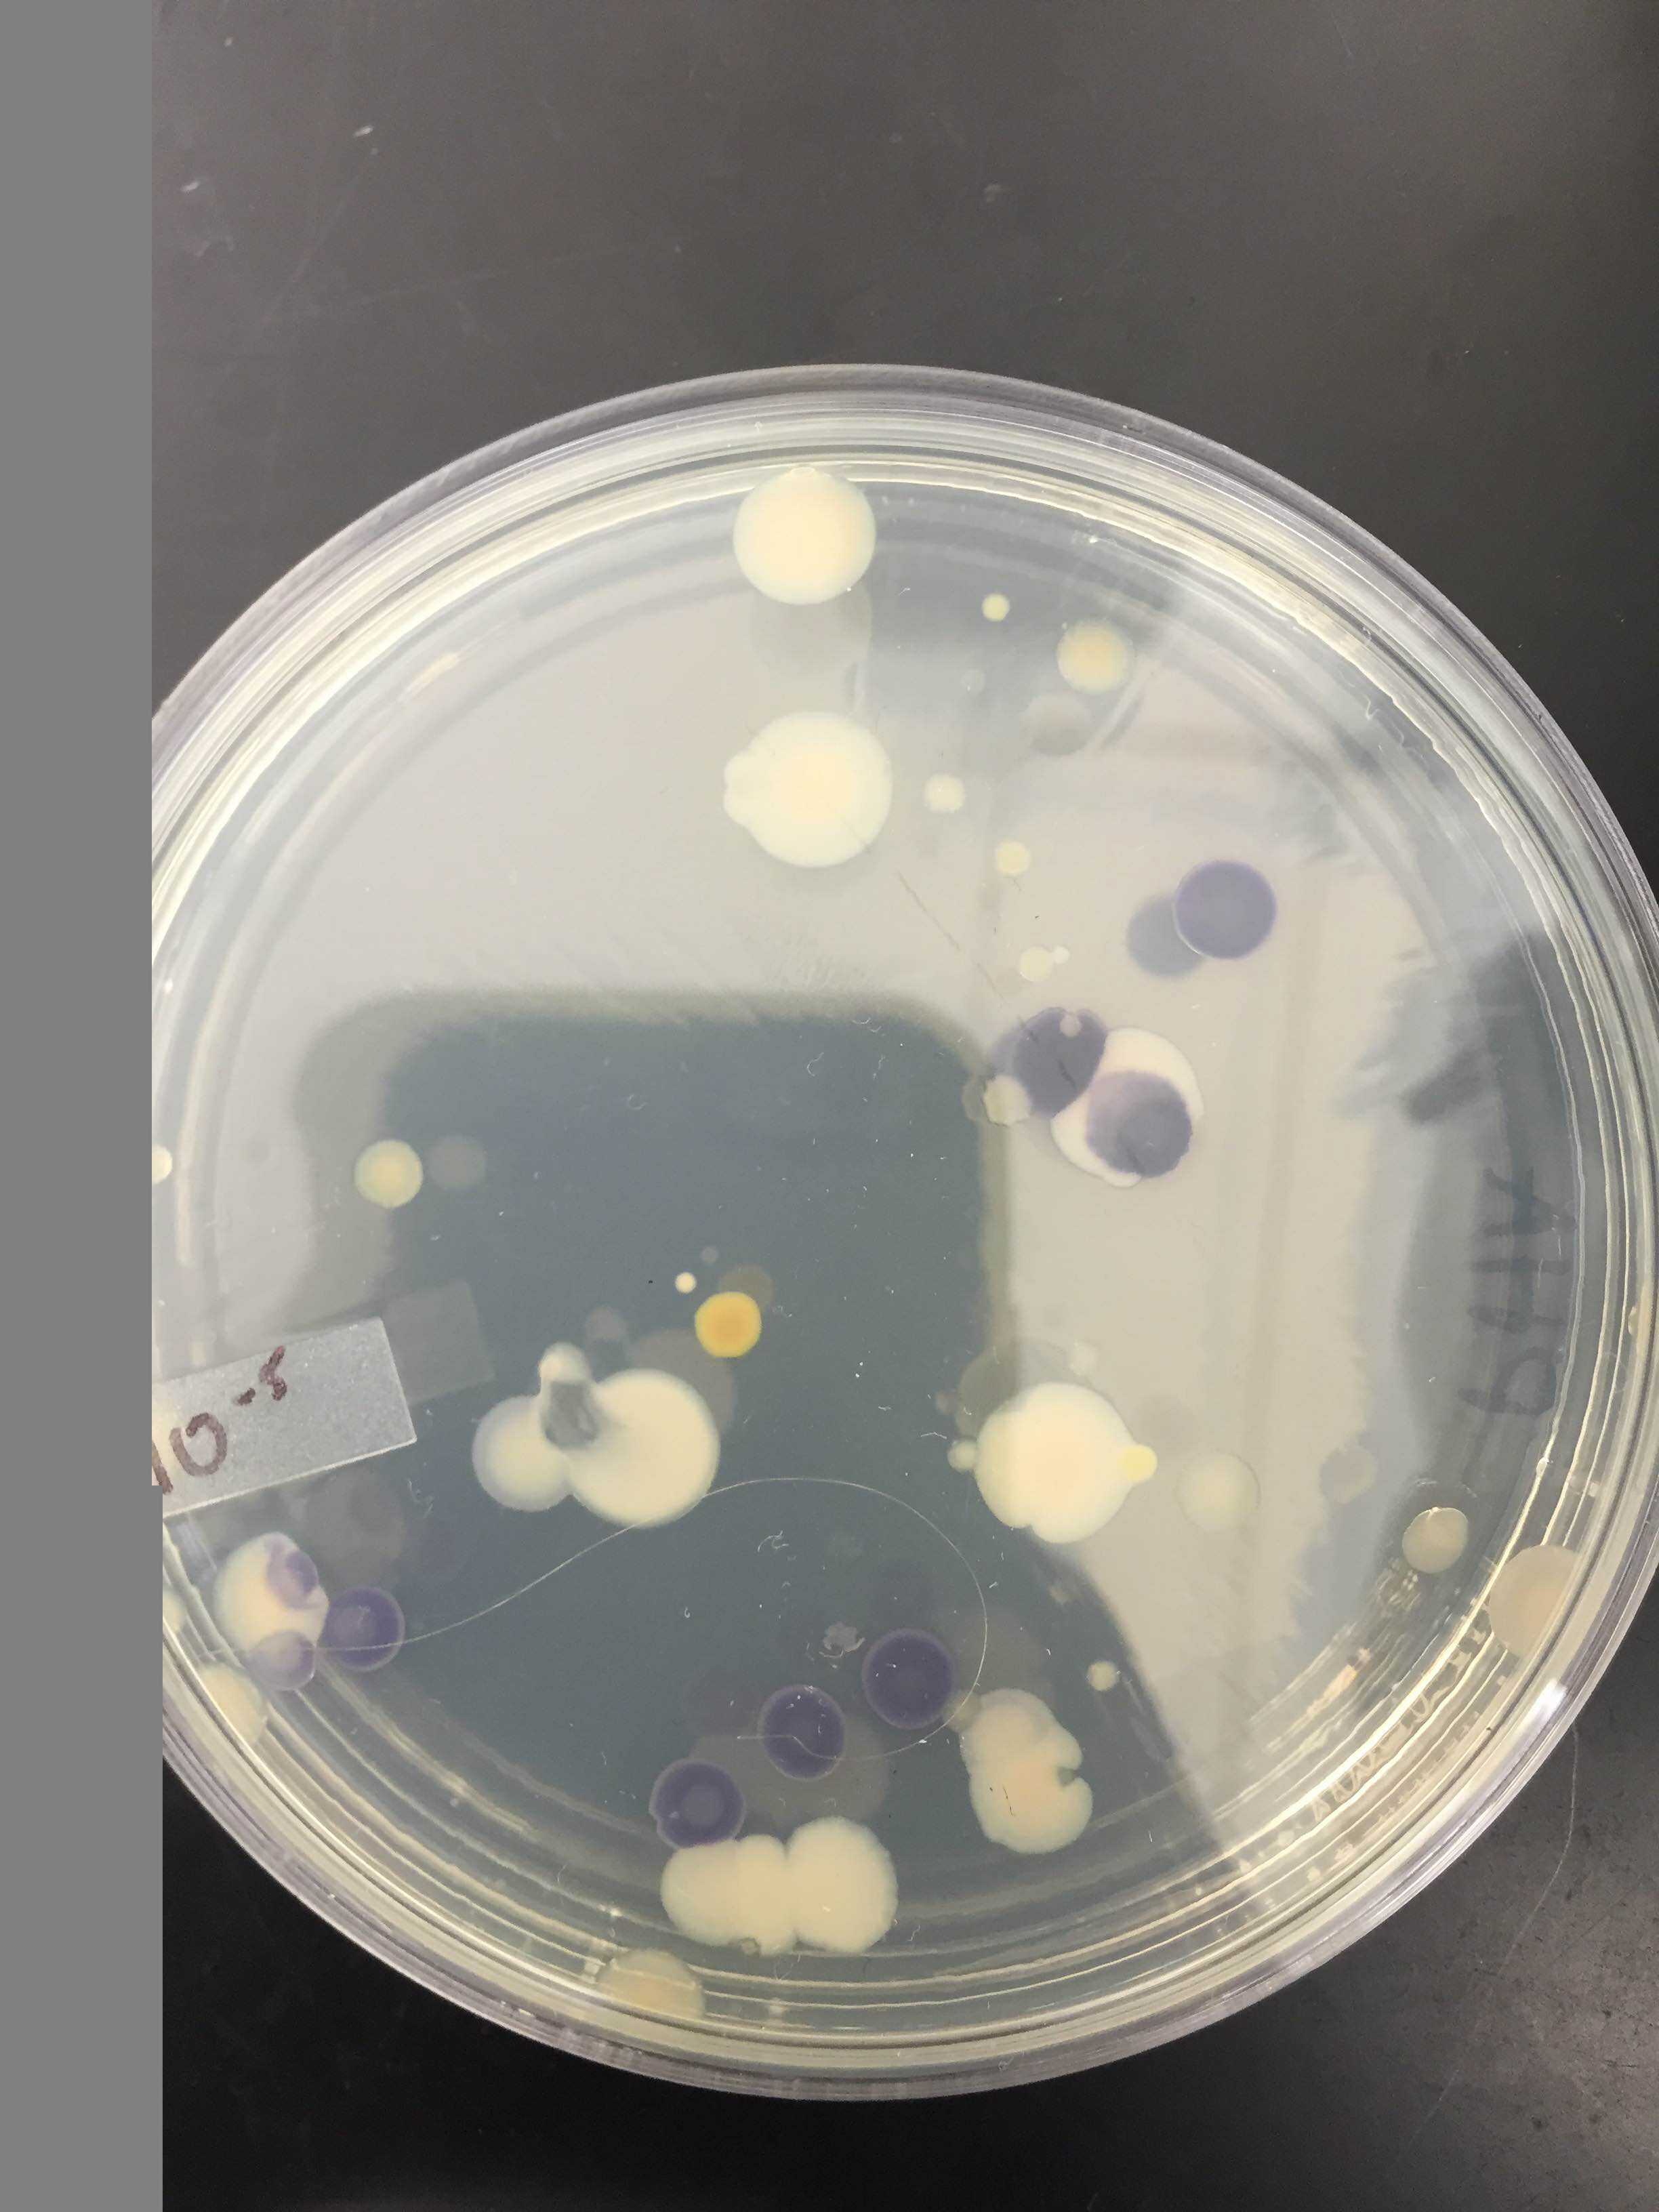

User:Hussain A. Khalfan/Notebook/Biology 210 at AU
March 10, 2016: Vertebrate Analysis and Food Web
Purpose:The purpose of this lab was to learn to identify types of invertebrates from the Berlese Funnel using a dichotomous key within our transact. Additionally, we learned how to identify and describe the morphological differences between acoelamates, pseeudocoelmoates and collimates as well as between radial, bilateral and no symmetry.
Materials and Methods: - Two plastic bags - Samples from five plants from transect - 500 grams of leaf litter - Parafilm -tape - screening material - Berlese Funnel - Ring stand
Table 1: Invertebrates found in Transect 3
Organism (Phylum+Class) Length in mm Number in sample Description of organism Arthropod, Insect 3 1 Little fly, has wings Arthropod, Insect 2 1 Looks like lice, curvy back Arthropod, Insect 2.5 1 Flea, compressed legs for jumping
Identification of Vertebrates found in Transect 3: There were no vertebrates found in this transect probably due to the fact that it was studied in the dead of winter, and the vertebrates that did inhabit the transect migrated to a more practical habitat to survive. However, there were a couple of invertebrates found in the transect. Invertebrates found include Fleas Siphonaptera, and annelids. However, from obeservatation of similar prairies in warmer conditions, vertebrates capable of living or passing through include birds, snails, squirrels, spiders, beetles, frogs, rats, salamanders and rabbits. Deers, skunks and raccoons are bigger vertebrates that are not frequently seen around campus, however, they can also be present.
This food chart represents the balance that must exist between the organisms within our transect. As a community, they maintain the structure of their ecosystem. If there was ever too many of one organism, carrying capacity would be reached and their environment could no longer support them all. For example, say that there was an influx of secondary trophic level organisms that relied on primary level trophic organisms for sustenance. The primary trophic level would suffer because they would be devoured at a much faster rate. Less of these organisms means a lesser food supply for the species that has reached carrying capacity. They will begin to die off as well until balance has been achieved. It is in this way that the balance of the ecosystem is maintained, allowing for all of the organisms to flourish in controlled growth.
Food Construction Web:

Conclusion: All organisms identified were arthropods ranging from 2-3 mm. They give us a "fuller" picture of transect three and allowed the construction of a food web. Together, these organisms fulfill the ecological concepts of "community", "carrying capacity" and "trophic levels".
ZebraFish Experiment:
Monday, February 22 Observation
with dissection microscope
the most mature looking embryos looked like 48 hours after fertilization
Control Group:
Hatched: A1, A3, A5, A6
B1, B2, B6 (Fungi in 2)
C1, C5 (fungi in one)
D1, D2, D5, D6 (fungi in D3 and D4)
so more than half have hatched
Control embyros have more pigmentation ( kind of green ish)
Fluoride babies: Hatched: none in row A B1, B4 C2, C3, C4, C5 D1, D2, D3, D5, D6 Less than half have hatched
Wednesday February 24th Observation
Observations with Dissection microscope
Control Group:
All fish in Row 1 are motile and have a slight green pigment. Some are moving very much.
All fish in row 2 are motile with slight green pigment
All fish in row 3 have a green pigment, some are motile
All fish in row 4 have a green pigment and some are motile.
Experimental Group: A3 has not hatched. Only one fish in row A is very motile and swimming around. (all have slightly lighter pigment) B1 and B2 fish are transparent. C6 has not hatched. All other fish in row C are hatched, motile, and have lighter pigment. D4 is not hatched. none in row D are really motile. all have lighter pigment.
Observations with Compound Microscope hes a cutie
Day 7 observations: 2/26/16 Dissection microscope control group In A4, there was only fungus All the other ones are born and alive - B3, B4, B5 never had any zebrafish in them C4 never had a fish D3 and D4 never had a fish either There was more fungus in control group than in experimental group
Experimental Fluoride Group
dissection microscope
A2 died
B3 and B4 died
B1 is completely deformed… the body shape is all fucked up and (eyes)=”what are thoooseeeee”... seizing/ shaking uncontrollably… most of its body is clear
C6 es finito. dead
D6 eyes have gold in them
Control Observation with Compound Microscope 2/22/16
Fish from D2 at 4x body and tail have green pigmentation eye: 0.8 micrometers eye movement: motile heart: dont see anyhting pectoral fin is developed and is quickly fluttering yolk sac: 8-9 micrometers
Experimental fish
D3 fluoride D2 control
degree of body and tail pigmentation: eyes: Eye movement: heart and heart rate: pectoral fin development: yolk sac size (adsorbed days 5-7): development of swim bladder: Development of mouth:
March 3, 2016 16S Sequence Analysis
Purpose:The purpose of this was to use DNA from the PCR and the gel electrophoresis to determine the actual bacteria present. This allows for an understanding that dichotomous keys, which are helpful, are not the be-all-end all of determining a species.
Materials and Methods: After performing the PCR and gel electrophoresis, the specimens were sent off to be analyzed. Bacteria fem transect 3 was analyzed and returned along with and iD sequence number. The sequence is:
Sample D: MB66 NNNNNNNNNNNNNNNNNANANTGNANNCCNNAGCGGTAGCAGANGNTATCANGATGTCCGACAGCGGCTTGCNGATGAGG TACAAGTGTGGTTTATGCCTTTAGCCGGGGGAGGCACTTTCGTTGGGAAGATTACAACCCCATAATTATAATCGTGGCAT CTCTTGAAANGGACTGGTCCAGTGGAAAAAGAAGGGCCCGACCCTGATGANGCAGTTGGTACGGGGACGGTTCACCANGG CTGTGATGTTTGTGGGGCCTGANAGGGTGATCCCCCTGTGTGGTACGGAGACATTGACCCAACACCAATTGCAGGCGCCT CTGAGGAATATTGGACAATGGGTGAGAGCCTGATCNNNANTCNNCGNGAAGGATGACGGTGCTCCTGGTTGTATTCTTCT TTTGTATATTGATGGTGATTTCCTCGTGGGTGAAGCTGAATGAACTATACAAGCAGNAACCGGNGAGGCCCNTGCCTTCA GCCTCGGTNNTACNCAGGGTGTTGCCGTTTGAGAGATTTATTGNNTTNTCGAGGTTGGTTCNNGCNGANGGCNNACAATA TGCTGTANNNNTNACTNNNNGGTCAATCTGCATANGTTGGCGCGNGNCGCGACTNTTGGATATCTACCTTGCNTAAAANA NTCNNACANGGAANNCNTANATAATANCNNNNNCACCAATTGCGAANGCAGGTTACTATGTCTTAACTGACGCTGATGGA CGAAAGCGTGGGGAGCGAACAGGATTANATACCCTGGTANTCCACGCCNTNNNNNATGCTNACTCGTTTTTGGGNTCTTC NGATTCAGAGACTAAACNAAAGTGATAAGTTAGCCACCTGGGGAGTACGTTCNCAAGANTGAAACTCNAAGGAATTGACN GNNCCCGCACAANCGGNGGATTATGTGNNTTNATTCNATGATACGCNANGAANCCTTNNCCNANGCTTAANTGGGNANTN GATCGGTTTNNNANNNNACCTTNCCTTNNNCAATTTCAAGGTNCTGCATGGNTNGTCNNCNGCTNNNNCCNNNANTNNNA GNTAANTCCTGNNNNNNNGNNNCCCCNTGTCNCNNN
was entered into an NCBI database and then analyzed further to determine what species it could be.
Data: The Chryseobacterium had an 85% identity to a gram-negative bacteria
Conclusion: Since we did not have enough sample we took the sample results from a previous section that was assigned to transect #3 and put the sample in the website Blast and our results were that a bacteria found in that transect is Chryseobacterium, which is a gram negative bacteria, which is consistent with the information found in our transects.
February 12, 2016- Plantae and Fungi
Purpose:the primary purpose of this lab is to show the unique characteristics of plants that have evolved by understanding the diversity in the transect. We will characterize and differentiate plants and fungi and learn the difference between angiosperms and bryophytes. We also studied the reproductive part of flowers and learned about alteration of generation
Materials and Methods: for this experiment, we began by collecting five plants from different parts of the transect, observing them using microscopes and then using the lab information to characterize them. We had to collect at least 500 grams of leaf litter. This litter was used for the Berlese Funnel to collect invertebrates. We characterized the vascularization and leaves of each plant in our transect and then identified the leaves as each plant as monocot or dicot.
Data and Observations:
- Plant characterization table
[[Image:IMG_0857.png]- this was microsporidia, the other type of fungi we found
 - this is a picture of the type of litter in our specific transact
- this is a picture of the type of litter in our specific transact
 - The fungi we found was basibycodia in our sample
- The fungi we found was basibycodia in our sample
Conclusion: This study found that in our transect, we had a mix of angiosperms and bryophytes. Three of the plants were dicot and two were monocot. In all of our plants, a stomata was present and was identified using the chart from lab. Next week’s lab will determine the different invertebrates living in our transect.
Febrary 5, 2016: : Identification of Fungi and Algae- we collected 500g of leaf litter
Materials and Methods: We started by collecting five plants from different parts of the transect, then observing them under the microscope, and using material in lab to characterize them using tables.
This is a picture of the PCR amplification:
January 29, 2016: Identifying Hay Fusion Bacteria
Purpose: Hay Infusion bacteria are based off of four main components; motility, gram stain, colony morphology and sequencing of the 16s ribosomal subunit gene. This gene sequencing will be explored further in next week’s lab. While observing the diversity of the Hay Infusion, the top layer was dark green brownish and was starting to form a layer of mold on top. It still smelled, however, like fresh body of water. From this astute observation, we can see that there will be no Achaea in our Hay Infusion sample, as Achaea are only found in extreme environments- none to which AU possesses.
Materials and Methods: We used the dichotomous key to identify the sort of bacterial organisms that grew in our Hay Infusion. We observed the growth on the agar plates at the following dilutions: 10^-5, 10^-7. Two from the nutrient agar plate and two from the nutrient agar plate plus tetracycline were observed under the microscope as 40x objective lens. Lastly, PCR was set up for 16s amplification, in which each of the sequences are specific to each species.
Results: Please see the results of the bacterial growth over one week on the agar plates below. The growth of bacteria was significantly inhibited by tetracycline. The 10^-7 and 10^-9 T plates has no exhibit of colonies as there were none. The most colonies were found on the nutrient agar type with 10^-9 at 9,000,000 colonies, 10^-7 at 220,000,000 colonies, 10^-5 at 4,000,000 colonies and 10^-3 at 124,000 colonies. Since the four colonies we looked at were gram positive.
‘gram-positive’ is a term used by microbiologist to classify bacteria into two groups (gram-positive or gram-negative). This positive/negative reference is based on the bacterium’s chemical and physical cell wall properties.(FermUp)
The next eight images are from our bacteria through the microscope. There was presence of both bacillus and Cocci in our samples.

 10^-5T colony (as you can see there are only 2)
10^-5T colony (as you can see there are only 2)

Table 1: 100-fold Serial Dilutions Results

Colony Label Chart (for four agar)

Conclusion: The bacteria from the Hay Infusion were all gram positive and produce blank blank This lab is important because it helps to learn and define characteristics of bacteria as well as differentiate the different kind of bacteria. The differences and similarities can be studied to conclude phylogenetic relationships. More will be known about the bacteria species, once the results from the PCR that were taken come back.
Works Cited: http://fermup.com/blog/what-does-gram-positive-mean/
-HK
January 22, 2016: Algae and Protists'
Purpose: Our Hay Culture Infusion was made by transect 3, which was located in the gardens right behind the amphitheater. The sample was made from the soil in our sample, 500 mL of water, and 0.1g of dried milk and laid outside for approximately a week before careful observation. Our infusion was very dark with clumps at the bottom, indicating there was a form of life as well as algae and protists present in the sample. Surprisingly, the culture did not contain a stinky odor, but smelled rather like pond water.
Materials and Methods: Samples were drawn from three different areas of our Hay Infusion- the bottom, middle and top. The samples were then put into a petri dish using a dropper and observed under the microscope. The organisms were identified using a dichotomous key. Through the use of our dichotomous key, we observed that our first sample was green, with pink along the edges and was moving quite rapidly and possessed flagella. We classified these algae as Euglena. Next, we chose a sample from the middle of our hay culture, which was labeled niche #2. This sample proved to be Gonium, as the sample was flat shaped and had many colonies. The third sample was a bit strange. We could not come up with a name for our niche # 3 but we can describe it. Almost like a diamond shape, this silver colored specimen with maroon brown spots and small white circles in the back just could not be identified. This could be a possible source of human error.
Conclusion and Future Directions: After careful observations of the Hay Culture Infusion under the microscope, we concluded that our sample from the transect is very diverse, containing both Algae and Protists. After taking various samples, we concluded that it contained different types of protists such as neospora and cytosporia.
January 15th, 2016: Observations of a Transect
Purpose: The purpose of this experiment was to observe the biotic and abiotic components within our specific 20 by 20 meter transect at American University. Additionally, we collected dirt, soil, leaves and woodchips in order to make our “Hay Fusion”.
Materials and Methods: While at the 20 by 20 meter transect, we sketched an ariel view of our transect, using a clipboard, paper and a pencil. We then filled up a plastic bag with soil samples from the area. Procedure two was the creation of the Hay Infusion sample by taking 10-12 grams of the soil sample and mixing it with 500 mL of Deerpark water, adding 0.1g of dried milk to the mixture and then letting it sit. Procedure three consisted of looking at three types of algae- Gonium, Volvox and Chlamydomonas, and observing their shape, size and colony size.
 The following abiotic and biotic factors were found: soil, leaves, woodchips and weeds
The following abiotic and biotic factors were found: soil, leaves, woodchips and weeds
Conclusion and Future Directions: Transect three had many biotic and abiotic factors. I presume that the three algae mentioned above-; Volvox, Gonium, and Chlamydonious could be present in the sample, however, further experimentation is needed.
Week 6: Invertebrates
Purpose: The purpose of this lab is to show the range of diversity in the invertebrates of transect three using a Dichotomous Key as well as to learn about the symmetry of animals and discover the differences between protostomes and deuterosomes, as well as coelomates, accoelamates and pseudocoelomates
Methods and Materials: The Berlese Funnel was set up a week prior so, it was taken apart this week. The top of 10-15 mL of 50% ethanol and organisms were poured into two petri dishes in order to be examined using microscope. The identifications were done using the sources given in the classroom.
Data: Table 1: Invertebrates found in in Transect Four
Table one compiles information regarding the invertebrates found in the transect. Three Insects were identified from the transect. There was one of each. One was a fly, identified via wings and an antenna. One was lice, identified via pointy head and curved back. A third, a flea, was identified through compressed legs used for jumping. All were 2-3 mm in length, with the lice being the smallest.
File:Flea.png This is a picture of the Flea under the microscope File:Lice.png This is a picture of the lice under the microscope
Koi Fish inhabit the pond in transect four. Koi fish are omnivores; they feed on different things in different stages of their life (Wohlgemuth, 7).
Muskrats are primarily herbivores, though they would also feed on animals. They eat insects, plants, algae, and other organisms (Wohlgemuth, 7).
Painted Turtles feed on plants and some invertebrates like the ones found in transect four (Wohlgemuth, 7).
Barn swallow feed on insects (Wohlgemuth, 6).
The Red-winged Black Bird eat both plants and animals (Rosenthal).
The five vertebrates that might live in the transect, with their full classification and taxonomy are described in the chart below

Conclusion: Most of the invertebrates found are arthropods. They were mostly bilateral, brown, had shorter legs, and all were 2-3 nm. Based on the samples it can be concluded there are diverse insects, but not invertebrates in general. The insects found include fleas, chewing/sucking lice, termites, and ticks. This data gives us a better understanding of transect 3 and allowed us to construct of a food web to give us a better understanding of “trophic levels”, “carrying capacity and community”.
Citation:http://animaldiversity.org/accounts/Agelaius_phoeniceus/